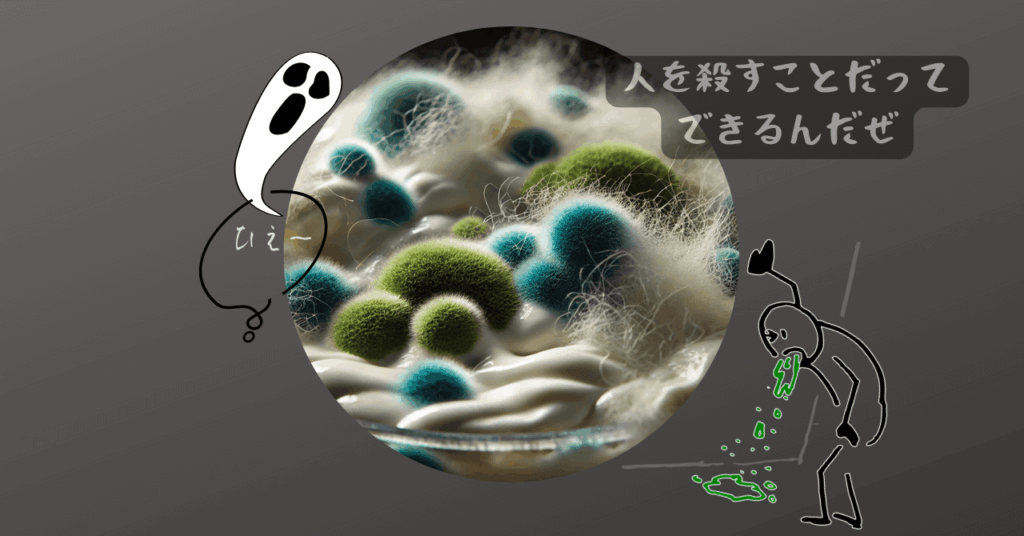
カビブログのアイキャッチ

😢【ヨーグルトやバターミルクに付くカビ】自家製は特に注意が必要❕
冷蔵庫から取り出したヨーグルト。さあ食べようとフタを開けた瞬間、「あれ…? なんか変かも…これ、カビかな.....」と思ったことってありませんか?
実は、ヨーグルトやバターミルクにつくカビは、初期のうちは目に見えにくいため、気づかずにぽいっと口にいれてしまうことも。
そこでこのブログでは、カビを食べてしまわないための見分け方、発生を防ぐコツを分かりやすくまとめました。
安全においしく乳製品を楽しむために、ぜひチェックしてみてくださいね。
ヨーグルトに付くカビは種類によって違う?市販・個別パック・自家製の違いとは

カビの生えやすさやリスクは種類によって違うんです。実際にヨーグルトにカビが生えるとしたら、どのような環境や条件が考えられるのでしょうか?
ここでは、市販のヨーグルト(未開封・個別パック・大容量)と自家製ヨーグルトに分けて説明していきます。
市販のヨーグルト(未開封)
スーパーで購入した市販ヨーグルトは、未開封で保存されてあれば雑菌が入りにくいため、基本的にカビが生えることってなかなかないんです。
そのため、賞味期限を数日過ぎても食べられることは多いのですが、これを過ぎると風味が落ちたり、ごくまれに異変が生じることもあるため、安全のためには、賞味期限から1週間以内を目安に食べきったほうがいいです。
個別パックのヨーグルト
小分けタイプ(3~6個セット)
1回で食べきれるから、カビの心配はほとんどなし!でも、一度開けると空気に触れるし、スプーンが汚れてるとカビが生えやすくなるんです。そのため、清潔なスプーンを使って、開封後は1~2日以内に食べるのが◎。
大容量タイプ(400g前後)
これ、要注意!何度もスプーンを入れるし、家族でシェアすると雑菌が入りやすくて、カビが生えやすくなるんです。特に*口をつけたスプーンで直接すくうのはNG!必ず清潔なスプーンを使うように心がけましょう。
自家製ヨーグルト
手作りのヨーグルトは、ヨーグルトメーカーで作る、カスピ海ヨーグルトのようにヨーグルトメーカーで作る、種菌を移してヨーグルトを作る、などどんな方法をとろうが、カビが生えてくるリスクは大いにあり。
これは発酵の過程で外気や器具から雑菌が混入しやすいため、市販品よりもカビが発生しやすいからなんです。特に、保存容器や道具をしっかり消毒していない場合、カビが生えるスピードが早まることも。
自家製ヨーグルトは1週間以内に食べきるのが理想で、保存容器やスプーンを徹底して清潔に保つことが、カビを防ぐためにめちゃくちゃ大事になります。
ヨーグルトに生えるカビの色とは?赤カビ・黒カビ・緑カビの見分け方と危険性
ヨーグルトやバターミルクに生えるカビを見逃して、食べてしまうことがないようにカビの成長過程を整理しておきます。
初期段階(ピンク色)微生物が少ない

- 表面にうっすらと薄いピンクのシミや斑点が現れる
- 「ちょっと色が違う?」程度で気づきにくい
- 目の錯覚かと思って放置すると、どんどん色が変化
ヨーグルトやバターミルクの表面に現れる薄いピンク色のシミや斑点は、主に以下のような微生物や成分が関係しています。
酵母や細菌が作り出す色素
ピンクや赤みを帯びたカビやシミの正体は、特定の酵母や細菌が生産する色素であることが多いです。
ロドトルラ属(Rhodotorula)酵母:
この酵母は赤~ピンク色の色素(カロテノイド)を作り出し、ヨーグルトやバターミルクの表面に発生することあり。冷蔵庫の中でも生育できるため、低温環境でも増殖しやすいのが特徴。
ロドトルラは、赤色酵母菌の一種で、空気中を普通に漂っている常在菌。「ピンクカビ」とも呼ばれるけど、実はカビじゃなくて酵母菌なんです。
酵母菌には、パンの発酵に使われるものもあって、意外と私たちの生活に役立ってるものも多いですよね。なのでカビとは違って、直接健康に悪影響を及ぼすことは少ないとされてます。また、この酵母菌(ロドトルラ)がピンク色に見えるのは、増殖するときに赤い色素を出すからなんです。
セラチア菌(Serratia marcescens):
これは、赤い色素(プロジギオシン)を作る細菌の一種。水回りや食品に発生しやすく、特に温度や湿度が高いと繁殖しやすいです。この菌が増殖すると、ヨーグルトやバターミルクの表面にピンク色のシミや斑点ができることも。
セラチア菌は「常在菌」のひとつで、普段はどこにでもいるし、特に害はないんです。この菌の特徴は水、土壌、植物、食品、さらには病院環境などにもみられます。また、健康な人の皮膚や消火官にも存在して通常は無害。
が、問題はあなたの免疫力が落ちたとき!
普段はおとなしくしてても、免疫が低下する*「日和見感染」(ひよりみかんせん)した体に悪影響を及ぼすことあり。実際に、過去には病院内で繁殖し、死亡例も出ているくらい、油断できない菌なんです。
*日和見感染(ひよりみ かんせん):健康なときには問題を起こさない細菌やウイルスが、免疫力が低下したときに感染して悪影響を及ぼすことを指してます。
例えば、セラチア菌は普段はおとなしいのに、風邪をひいたり、ストレスや病気で免疫力が落ちると、それにつけこんできて、あなたのカラダは感染しやすくなるんです。そのため、病院での感染症の原因にもなることも。特に、高齢者や赤ちゃん、持病のある人、入院中の人は注意が必要です。
乳成分の酸化や変質
カビや細菌ほど目立つものではないんですが、保存期間が長くなるとヨーグルトやバターミルクに含まれる乳脂肪やたんぱく質が、空気や微生物の影響で酸化・変質することで、うっすらとピンクがかった変色が見られる場合があります。
中期段階(赤色に変化)ピンクが濃くなり赤色へ・増殖+色素の蓄積

- ピンク色がだんだんと濃くなり、赤い斑点や模様がはっきりしてくる
- 特に容器のフチや、スプーンを入れた部分から広がりやすい
ピンク色がだんだんと濃くなり赤い斑点や模様がはっきりしてくる のは、カビや細菌の増殖と色素の蓄積が関係しています。
微生物(カビ・細菌・酵母)が増殖することで色が濃くなる
微生物が生産する色素は、時間が経つと酸化することがあります。酸化によって色がより濃くなり、最初は淡いピンクだったものが、より深い赤色へと変化します。
色素は時間の経過とともに酸化が進む
最初の淡いピンク色が深い赤色に変化してくる要因は以下:
- 温度が高い(10℃以上):微生物の成長が促進されるため
- 空気に触れる:酸化が進みやすくなるため
- 保存期間が長い:色素の蓄積が進み、変色が加速するため
他の微生物との相互作用
微生物は、単独で増殖するだけでなく、他の微生物との相互作用によってさらに色の変化を引き起こすことってあるんです。
例えば、最初にロドトルラ酵母(ピンク色)が増殖した後、別のカビ(赤カビや黒カビなど)が加わると、色がさらに濃くなり、
赤や黒の模様が混ざることがあります。
また、ヨーグルトやバターミルクに含まれる乳糖やたんぱく質を利用することで、微生物の増殖が促進され、赤カビの広がりは加速していくんです。
後期段階(黒カビ・緑カビの発生)鮮やかな赤~黒色へ(酸化+他の微生物の影響)

微生物の進化と環境の変化により、ヨーグルトやバターミルクの表面に赤カビが生えたまま放置すると、黒カビや緑カビが現れ始め、やがてフサフサとしたカビのかたまりが広がり、周囲を覆うようになっていきます。
黒カビ(Cladosporium・Aspergillus属)— 強力なカビの王者
- 赤カビが劣化していくと、その後に黒カビが現れやすくなる
- 成長するにつれ、メラニン色素を含む胞子を大量に作り出すため、黒く見えてくる
- 黒っぽい斑点から、やがて広がってモワモワとしたコロニーを形成する
緑カビ(Penicillium属)— 実は抗生物質の元になるカビ
- 緑カビは、青カビ(Penicillium)とも呼ばれ、「クロロフィルに似た色素」を含むため緑色になる
- パンや果物にもよく発生するカビ
- 特徴的なのは、綿毛のようにふわっとしたコロニーを作ること
- ペニシリン(抗生物質)の元になったカビだが、食品に生えたものは有害なので食べてはいけない
- 最初は白→次第に淡い緑→濃い緑へと変化していく
また、ヨーグルトやバターミルクの表面に生えたカビが時間とともにフサフサしてくるのは、胞子を広げるための「菌糸」が成長するから。カビは「菌糸(きんし)」と呼ばれる糸のような構造を持っており、成長するとこれが密集し、フワフワとした毛のように見えはじめます。
また、カビは増殖する際に胞子を飛ばして仲間を増やすため、フサフサとした形状になるほど胞子を遠くに拡散しやすくなります。つまり、カビがフサフサしてきたということは「もう手遅れ」のサイン。この段階まで進行すると、カビは食品全体に根を張っている可能性が高いため、すぐに捨てるのがベストです。
カビが原因で起こる「食中毒」や「アレルギー」のリスクとは

カビは、食品や建物に広がることでさまざまな健康リスクを引き起こす可能性があります。食中毒や長期的な健康問題を引き起こす原因となります。さらに、カビによるアレルギー反応も無視できない健康リスクです。
マイコトキシン(カビ毒)による食中毒
一部のカビは、マイコトキシンという有害な毒素を作り出します。これらを摂取すると、肝臓や腎臓の障害、神経系への影響、免疫低下などを引き起こす可能性があります。特に、アフラトキシンやオクラトキシンなどは強い毒性を持ち、発がん性が指摘されています。
胃腸炎
胃腸炎の原因は多岐にわたりますが、カビによる食品汚染はその一つとして重要です。特に「マイコトキシン」と呼ばれるカビ毒が問題となります。これらは消化器官にダメージを与え、下痢や吐き気、腹痛を引き起こすことがあります。カビが繁殖した食品を食べることで、次のような問題が発生します:
カビに汚染された細菌
カビが食品に繁殖すると、その表面に細菌が付着し、これが感染源となることもあります。特にサルモネラ菌や大腸菌などが問題となり、これらの細菌は胃腸炎を引き起こす原因となります。カビが繁殖した食品を食べると、下痢や嘔吐、腹痛などの胃腸炎症状を引き起こすことがあります。これは、カビそのものや、カビに汚染された食品内の細菌が原因になることがあります。
アレルギーのリスク
カビによるアレルギー反応は、喘息やアレルギー性鼻炎を引き起こすことがあります。カビの胞子が空気中に浮遊し、体内に取り込まれることで症状が現れることが多いです。
皮膚炎やアレルギー反応
カビに触れることで、皮膚がかぶれたり、赤みやかゆみを伴うアレルギー反応が起こることがあります。敏感な人は、食品に触れた際に手袋をするなどの対策が有効です。
呼吸器系のアレルギー
カビの胞子を吸い込むことで、くしゃみ、鼻水、咳、喘息の悪化などの症状が現れることがあります。特にカビアレルギーを持つ人は注意が必要です。
まとめ:ピンクから赤、黒、緑へ…カビの変化に要注意!

ヨーグルトやバターミルクに発生するカビは、「ピンク → 赤 → 黒・緑」と変化します。この流れを知っておくと、初期段階で異変に気づきやすくなります。
カビが生えた食品はすでに腐敗しているため、すぐに処分しましょう。特に、カビがフサフサとした状態になっている場合、食品全体に広がっている可能性が高いため、決して口にしてはいけません。
カビを防ぐには、適切な保存が重要なため、冷蔵庫の温度を3〜5℃に保ち、空気に触れると雑菌が繁殖しやすいため開封後は密閉容器で保存しましょう。
また、清潔なスプーンを使い、カビが食品に付着しないようにすることも大切。誤って口にすると食中毒やアレルギーのリスクがあるため、少しでもカビが生えたら迷わず廃棄とするのがベストです。

